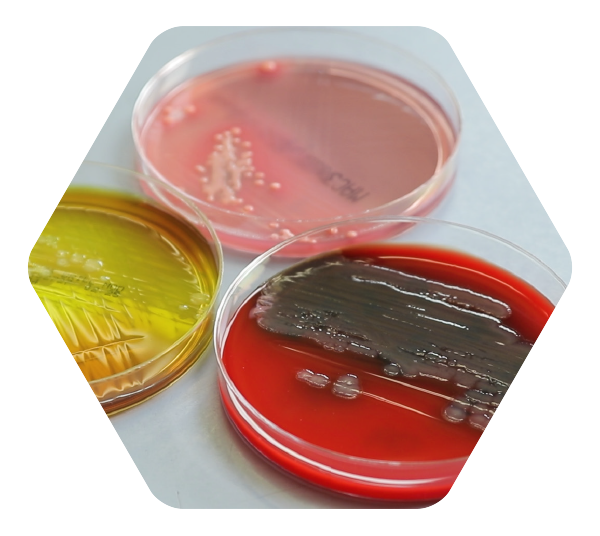

Zur Verstärkung unseres Teams suchen wir per sofort eine/n Laboranten (m/w/d)
für die Bereiche Lebensmittel, Wasser & Pharma in Vollzeit.
Deine Qualifikation
Abgeschlossene Ausbildung als Biologielaborant (m/w/d) oder vergleichbare naturwissenschaftliche Qualifikation (Fachkraft für Lebensmitteltechnik bzw. VMTA, MTA, BTA) oder Bachelorabschluss in einem relevanten naturwissenschaftlichen Studiengang (z.B. Biologie, Biotechnologie, Lebensmitteltechnologie).
Erfahrungen in einem akkreditierten Diagnostiklabor in der Bakteriologie oder Lebensmittelüberwachung. Kenntnisse in GMP, Qualitätskontrolle und /oder Virologie wünschenswert.
Bereitschaft zur Teilnahme an Wochenenddiensten.
Team- und Kommunikationsstärke, Flexibilität und eigenständiges Arbeiten sowie ein sicherer Umgang mit MS Office bzw. Laborinformationssystemen (LIMS).
Wir bieten
Eine abwechslungsreiche und verantwortungsvolle Tätigkeit in einem international ausgerichteten Unternehmen.
Ein engagiertes Team, flache Hierarchien und ein kollegiales Arbeitsumfeld.
Ein attraktives, leistungsbezogenes Vergütungspaket inklusive zahlreicher Zusatzleistungen, z. B. Wellpass (Firmenfitness), Bikeleasing sowie zusätzlicher Arbeitgeberzuschuss zur betrieblichen Altersvorsorge.
Die Stelle ist im Rahmen einer Elternzeitvertretung auf ein Jahr befristet.
Deine Aufgaben
Bakteriologie: Probenaufbereitung und Durchführung bakteriologischer Tests, Identifikation mittels MALDI-TOF.
Wasseranalytik: mikrobiologische Untersuchungen von Trinkwasser; der Bereich wird derzeit aufgebaut und soll zukünftig auch die Untersuchung von Lebensmittelproben umfassen.
Qualitätskontrolle: Prüflabortätigkeiten für die Pharmaherstellung.
